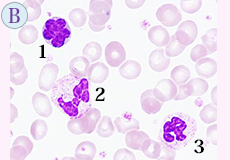

第52回 「マンスリー形態マガジン」 2015年8月号
『 執筆のチャンスを戴いて 』
前 略
今回は、急きょ執筆活動について最近のものと過去のものを少し振り返ってみたいと思います。 昨年は三冊目となる血液形態学書として「エビデンス血液形態学」(近代出版.2014)を出版させて頂きました。そして今年は、「白血病診療Q&A~一つ上を行く診療の実践~」(中外医学社.2015.4)と臨床検査「特集.血液細胞形態編判読の極意」(医学書院.vol.59,No.7,2015.7)において執筆のチャンスを戴きました。
前者は、監修された松村到先生(近畿大学医学部血液・膠原病内科教授)のご配慮によるもので、医師52名のなかに技師として加えて下さいました。Ⅰ-基礎事項:5.形態異常の定義とは? と6.形態異常から染色体異常を予測できるか ?(p23-33)を担当しましたが、1人では心細かったものですから、染色体・遺伝子にご専門の三浦偉久男先生(聖マリアンナ医科大学血液・腫瘍内科学教授)に加わって頂きました。以前、医師と共執させて頂いたなかに「三輪血液病学(第3版)」(文光堂.2006)があります。この時は、浅野茂隆先生(東京大学名誉教授)のご配慮によるもので、Ⅲ.白血球-A.顆粒球の形態(p262-276、カラー付図36枚)を担当しました。この成書は日本のそうそうたる血液学者143名が名を揃え、なんとページ数は2070、成書の厚さは6cm、価格は4,5000円とすべてビッグでした。
後者は、監修された佐藤尚武先生(順天堂大学医学部・大学院医学研究科)のご配慮によるもので、末梢血液像の観察ポイント(p664-671)を担当させて頂きました。「血液細胞形態判読の極意」というテーマでしたので、現場の技師が形態診断を行う上における問題点に着眼し、その打開策について取り組んでみました。
過去を振り返り、浅学の身ながら臨床の先生の枠に入らせて頂き執筆することができたことは名誉なことで、何よりも貴重な財産となっています。まだまだ、先を眺めて進みたいと思います。
草々
形態マガジン号キャプテン 阿南 建一 

松村 到 監修
(中外医学社.2015.4)

佐藤尚武 監修
(医学書院.2015.7)

浅野茂隆・池田康夫・内山 卓 監修
(文光堂.2006.1)

阿南建一 監修
(近代出版.2014.9)
今回のねらい
今回は末梢血液像および骨髄像の細胞同定と診断に挑みます。
細胞同定には共に正常なものから見逃してはいけないもの、また鑑別を要する細胞を提示してみました。
症例は稀なものであるが、周囲の類似疾患との鑑別には認識しておくことが必要です。臨床症状や形態学的特徴を持ち合わせた疾患でもありますので、類似疾患も考えながら診断を試みて下さい。
問題
末梢血液像の細胞同定をリストより選んで下さい。
骨髄像の細胞同定をリストより選んで下さい。
末梢血・骨髄像から考えられる疾患をリストより選んで下さい。
-
PB-MG ×1000

-
BM-MG ×1000

解答・解説
問題 1
(正解と解説)
末梢血液像の細胞同定です。ここでは、リンパ球と異常リンパ球そして好中球を出題しました。
【正解】
(CASE A) 1-③.異型リンパ球、2-②.リンパ球(CASE B) 1-④.異常リンパ球、2-⑥.分葉核球、3-⑥.分葉核球
【解説】

- (CASE A)
1.細胞径18μmの大型で、N/C比は低く、核形不整は軽度、核網工は粗剛、細胞質は部分的に好塩基性がみられることより異型リンパ球に同定しました。異型リンパ球の大きさは16μm以上とされます。
2.細胞径12μmの小型で、N/C比は低く、核はほぼ円形、核網工は粗剛、細胞質は強度の好塩基性がみられることより小リンパ球に同定しました。細胞質の好塩基性から異型リンパ球を思わせますが、小リンパ球はもともと好塩基性を有しており、何よりも小型であることが異なる点です。
- (CASE B)
1.細胞径10μmで、N/C比は高く、核形は顕著な不整、核網工は繊細で濃染状を呈することより異常リンパ球が考えられます。その条件としては周囲に同じような形態の細胞が散見または増加していることになります。すなわち、その状態は単一様式をとることになりますので異常リンパ球として同定します。形態学的にはATL細胞を考え、抗HTLV-Ⅰ抗体陽性などを検索します。
ただ、採血後の検体を長時間放置した後にリンパ球ではこのような形態像を呈することがありますので要注意です。
2.と3.は好中球になりますが、核のくびれとクロマチン結節が強いことより分葉核球に同定しました。
核の最小幅が最大幅の1/3未満(JAMLT.1996)の基準も有効になります。
問題 2
(正解と解説)
骨髄像の細胞同定です。ここでは、赤芽球系、骨髄芽球、単球を出題しました。
【正解】
1-⑤.多染性赤芽球、2-③.前赤芽球、3-⑪.フェラタ細胞、4-⑧.単球、5-①.骨髄芽球、6-⑩.分葉核球
【解説】

-
- 細胞径8μm、A-2.に類似しますが、核網工は結節状で細胞質は多染性の色調のことより多染性赤芽球に同定しました。
- 細胞径20μm大の大型、核はほぼ円形で、核網工は微細顆粒状、核小体は中央にあるようで、細胞質の舌状突起(2時方向)や好塩基性を有することより前赤芽球に同定しました。
- 一見、前骨髄球を思わせますが、細胞質の不整やアズール顆粒の大小不同や不均一性などよりフェラタ細胞に同定しました。この細胞は現在表に出ることはありませんが、豊富な細胞質と不整な細胞質も特徴的で、非造血細胞として捉える方が妥当かも知れません。
- 細胞径16μm大、核形不整がみられ、核網工は繊細、細胞質は灰青色で微細なアズール顆粒を有することより単球に同定しました。
- 細胞径17μm大、核は類円形、核網工は繊細で核小体を認め、細胞質は辺縁に沿って好塩基性を認めることより骨髄芽球に同定しました。
- 細胞径13μm大、クロマチン結節が強く、核の重なりがみられることより分葉核球に同定しました。
問題 3
(正解と解説)
【正解】
③.前リンパ球性白血病(prolymphocytic leukemia: PLL)
【解説】
(PB-MG ×1000)
(BM-MG ×1000)
- 臨床および検査データより、高齢、白血球数増加、脾腫がみられます。
ここには表記していませんが、脾腫は巨脾であり、リンパ節腫大はごく僅かに認められました。
白血球数は5日後には86,000/μLと著増し、末梢血に出現した異常細胞はPO染色に陰性で B細胞の性格を有し他にFMC7の陽性がみられたことより異常リンパ球として捉えました。
5日後の末梢血には異常リンパ球が85%出現し、骨髄には56%みられました。
異常リンパ球は、N/C比がやや高く、核形不整や明瞭な核小体を有し、細胞質には突起物もみられることより前リンパ球に同定しました。
整理しますと、高齢、孤立性脾腫、白血球数増加、B細胞、前リンパ球の増加(末梢血で55%以上)などの所見より前リンパ球性白血病と診断されました。
Galtonら(1974)の分類では、cleft typeと思われます。PLLはその昔、慢性リンパ性白血病(CLL)に分類されていたようですが、CLLでクローナルな増殖をする成熟リンパ球に比べ、PLLでは前リンパ球の増殖やリンパ節腫大を伴わない脾腫(孤立性脾腫)を示し、予後不良であることがGaltonらによって独立疾患として報告されました。 -
【PLLの分類 (Galton.1974)】
- ① classic type:大型細胞で、N/C比は中等度を示し、核は円形~楕円形で中央に位置し、クロマチンの凝集傾向、明瞭な核小体を有する。
- ② cleft type:均一性で、N/C比はやや高く、核形に切れ込み(cleft)を示す細胞が優勢で、明瞭な核小体を有する。
- ③ CLL like type:比較的小型で、N/C比は高く、核小体が不明瞭のためCLLと鑑別を要する。
これから先のページでは、医療関係者の方々を対象に医療機器・体外診断薬等の製品に関する情報を提供しております。当社製品を適正に使用していただくことを目的としており、一部の情報では専門的な用語を使用しております。
一般の方への情報提供を目的としたものではありませんので、ご了承ください。
医療関係者の方は、次のページへお進みください。
(お手数ですが、「進む」ボタンのクリックをお願いします)
